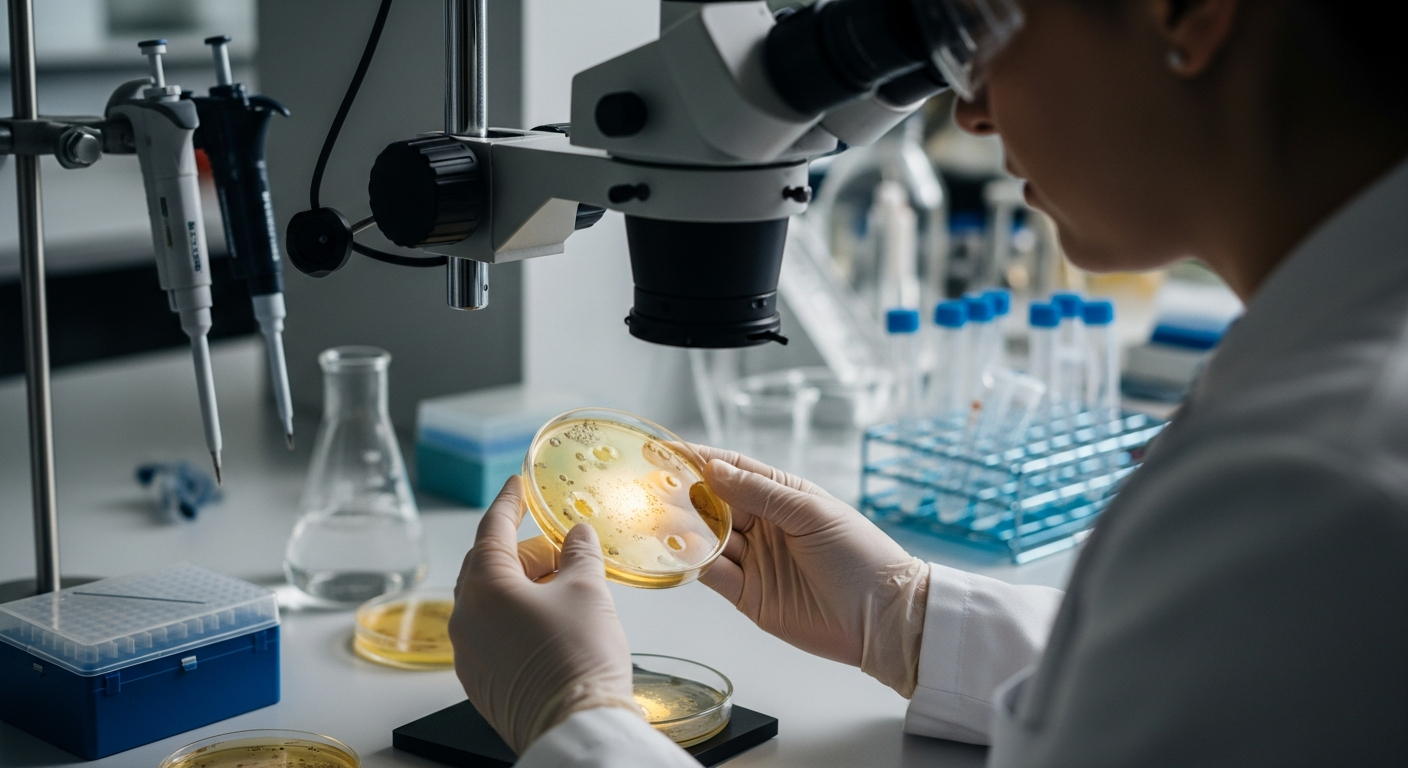

Impact de l'inflammation sur la santé digestive
L'inflammation est une réponse naturelle du corps à une blessure ou une infection, mais lorsqu'elle devient chronique, elle peut avoir des conséquences significatives sur la santé digestive. Ce processus prolongé peut affecter diverses parties du système digestif, entraînant une série de symptômes et de complications qui vont au-delà de l'inconfort immédiat. Comprendre le rôle de l'inflammation est essentiel pour appréhender les troubles digestifs et leurs répercussions sur le bien-être général.
Cet article est à titre informatif uniquement et ne doit pas être considéré comme un avis médical. Veuillez consulter un professionnel de la santé qualifié pour des conseils et un traitement personnalisés.
L’inflammation est un mécanisme de défense complexe du corps, conçu pour protéger l’organisme contre les agents pathogènes et réparer les tissus endommagés. Cependant, lorsque cette réponse inflammatoire persiste sur une longue période, elle peut se transformer en un état chronique, particulièrement délétère pour le système digestif. Cette inflammation intestinale prolongée peut altérer la paroi des intestins, compromettant leur fonction et leur capacité à absorber les nutriments essentiels. Les conséquences vont de l’inconfort localisé à des problèmes systémiques qui peuvent affecter l’ensemble du corps, soulignant l’importance d’une approche holistique de la santé digestive.
Qu’est-ce que l’inflammation intestinale et ses effets ?
L’inflammation intestinale se caractérise par une activation persistante du système immunitaire dans le tube digestif. Cela peut se produire dans différentes parties de l’intestin, de l’estomac au côlon. Cette réaction excessive peut endommager les cellules de la muqueuse intestinale, entraînant une perméabilité accrue de l’intestin, souvent appelée « intestin perméable ». Une telle situation permet à des substances indésirables de passer dans la circulation sanguine, ce qui peut déclencher d’autres réactions inflammatoires dans le corps. La digestion est directement impactée, car l’intégrité des tissus est compromise, rendant l’assimilation des aliments moins efficace et potentiellement douloureuse.
Symptômes digestifs courants associés à l’inflammation chronique
Les personnes souffrant d’inflammation chronique du système digestif peuvent éprouver une variété de symptômes. La douleur abdominale est une plainte fréquente, souvent décrite comme des crampes ou une gêne persistante. Les troubles du transit intestinal sont également très courants, incluant des épisodes de diarrhée fréquente ou, inversement, de constipation. Des nausées peuvent survenir, parfois accompagnées de vomissements, affectant l’appétit et la qualité de vie. Ces problèmes digestifs sont des indicateurs clairs que l’inflammation est active et perturbe le fonctionnement normal du tractus gastro-intestinal.
Impacts systémiques de l’inflammation digestive
Au-delà des symptômes purement digestifs, l’inflammation chronique de l’intestin peut avoir des répercussions sur l’ensemble du corps. La malabsorption des nutriments est une conséquence directe de l’altération de la paroi intestinale, pouvant conduire à des carences nutritionnelles importantes. Ces carences, combinées à la charge inflammatoire constante, contribuent souvent à une fatigue persistante et inexpliquée. Une perte de poids involontaire peut également être observée, résultant de la malabsorption et d’une diminution de l’apport alimentaire due à la douleur et aux nausées. Ces manifestations systémiques soulignent que la santé du gut est intrinsèquement liée à la santé globale.
Comprendre les troubles intestinaux chroniques
Les troubles intestinaux chroniques, tels que la maladie de Crohn ou la colite ulcéreuse, sont des exemples de conditions où l’inflammation joue un rôle central. Ces maladies sont caractérisées par des périodes de poussées inflammatoires alternant avec des périodes de rémission. La gestion de ces troubles nécessite souvent une approche multidisciplinaire, incluant des ajustements alimentaires, des médicaments anti-inflammatoires et, dans certains cas, des interventions chirurgicales. L’objectif est de réduire l’inflammation, de soulager les symptômes et d’améliorer la qualité de vie des personnes affectées. Une meilleure compréhension de ces affections est cruciale pour une prise en charge efficace et pour aider les patients à gérer leur santé à long terme.
L’inflammation dans le système digestif, qu’elle soit aiguë ou chronique, est un facteur déterminant de la santé et du bien-être général. En reconnaissant les symptômes et en comprenant les mécanismes sous-jacents, il est possible de mieux gérer les troubles digestifs et de minimiser leur impact sur la vie quotidienne. Une attention particulière à l’alimentation, au mode de vie et une consultation médicale appropriée sont des étapes clés pour maintenir un système digestif sain et fonctionnel. La recherche continue d’améliorer notre compréhension et nos stratégies de traitement pour ces conditions complexes.




